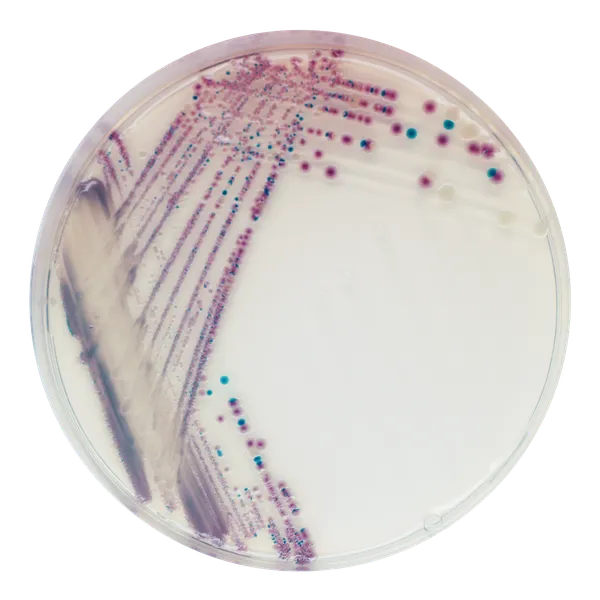
CHROMagar™ Vibrio

Hình thái khuẩn lạc

V. parahaemolyticus
Màu tím hoa cà

V. vulnificus / V. cholerae
Xanh lam-xanh lơ đến xanh ngọc lam

V. alginolyticus
Màu kem
Hiệu năng
Hiệu năng
Hiện diện tự nhiên trên các loại thực vật và động vật biển, chi Vibrio gồm hơn 20 loài trong đó có bốn loài là mối đe dọa nghiêm trọng đối với sức khỏe cộng đồng.
V. cholerae thường gây bệnh tả thông qua ô nhiễm nước và thực phẩm. Với tính chất lây lan theo chu kỳ, bệnh tả được coi là bệnh lưu hành ở nhiều quốc gia như một bệnh nhiễm khuẩn độc gây tiêu chảy nghiêm trọng và mất nước. Số ca bệnh tả được báo cáo với WHO năm 2006 tăng mạnh, đạt mức của những năm 1990. Khoảng 240,000 ca bệnh được báo cáo từ 52 quốc gia, bao gồm khoảng 6300 ca tử vong.
V. parahaemolyticus và V. vulnificus thường liên quan đến các bệnh truyền qua thực phẩm từ hải sản, gây nhiễm khuẩn huyết, nhiễm khuẩn vết thương và viêm dạ dày. CDC báo cáo sự gia tăng ước tính 47% của các ca nhiễm Vibrio ở Mỹ (1996-1998 đến 2008), khoảng 8000 bệnh hàng năm. Các ca nhiễm Vibrio cũng thường được báo cáo ở châu Á và châu Đại Dương, liên quan đến việc tiêu thụ hải sản cao. Mặc dù V. parahaemolyticus là loài được báo cáo nhiều nhất gây nhiễm khuẩn, V. vunificus trở nên ngày càng phổ biến và hiện nay liên quan với 94% số ca tử vong được báo cáo.
V. alginolyticus ít phổ biến hơn nhưng là mối quan tâm của các nhà sản xuất hàu vì nó có thể dẫn đến thiệt hại sản xuất lớn. Nếu phát hiện, nó có thể ngăn ngừa lây lan đến các khu vực sản xuất hàu khác.
1. Màu sắc khuẩn lạc rõ ràng và đậm: nhờ vào công nghệ chromogen mạnh mẽ của nó. Dễ đọc đặc biệt khi so sánh với môi trường TCBS truyền thống dựa trên sự lên men sucrose được tiết lộ bằng chỉ thị pH.
2. Thực tiễn :V. alginolyticus vẫn không màu trong CHROMagar™ Vibrio, tránh bất kỳ sự can thiệp nào với việc phát hiện các loài khác.
3. Phân biệt rõ ràng : giữa V. parahaemolyticus và V. vulnificus, cả hai đều sucrose (-) trên TCBS.
4. Mạnh mẽ : Không có đối thủ trong lĩnh vực môi trường chromogen.
5. Hiệu suất thu hồi xuất sắc : tốt hơn thạch TCBS, ngay cả khi sử dụng môi trường tăng cường. Ít dương tính giả hơn thạch TCBS.
Thành phần

Tài liệu kỹ thuật
Công bố khoa học
2022
Vibrio parahaemolyticus Isolates from Asian Green Mussel: Molecular Characteristics, Virulence and Their Inhibition by Chitooligosaccharide-Tea Polyphenol Conjugates
? Publication2022
Bacterial Content in Gut For Different Species of Fish Collecting From Tigris River in Baghdad City, Iraq
? Publication2020
Prevalence of Vibrio parahaemolyticus causing acute hepatopancreatic necrosis disease of shrimp in shrimp, molluscan shellfish and water samples in the Mekong Delta, Vietnam
? Publication2014
Vibrio parahaemolyticus: a review on the pathogenesis, prevalence, and advance molecular identification techniques
? Publication2012
Characterization of Vibrio spp. on CPC+, CHROMagar Vibrio, and TCBS, and Proposed Cross-Plating Method for Isolation of Vibrio vulnificus from Environmental Samples
? Publication2011
Prevalence and diversity of vibrio sp. from different sources in marine environment at Agadir and Essaouira (Morocco)
? Publication2011
Comparative evaluation of a chromogenic agar medium - PCR protocol with a conventional method for isolation of Vibrio parahaemolyticus strains from environmental and clinical samples
? Publication2011
Evaluation of different procedures for the optimized detection of Vibrio parahaemolyticus in mussels and environmental samples
? Publication2011
Comparison of two selective and differential media for the isolation of Vibrio vulnificus from the envir
? Publication2010
Comparison between thiosulphate-citrate-bile salt sucrose (TCBS) agar and CHROMagar Vibrio for isolating Vibrio parahaemolyticus
? Publication

Xem thêm